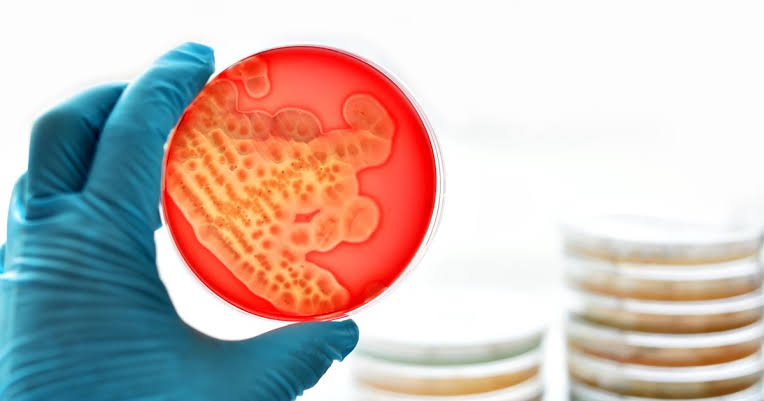

Un grupo de investigadores de la Universidad de Stanford en los Estados Unidos y Universidad McMaster en Canadá, creó una herramienta de inteligencia artificial (IA) que podría cambiar el panorama para el diseño de antibióticos fáciles de elaborar.
Su nombre es SyntheMol-RL y es un modelo generativo de IA eficaz para diseñar candidatos a fármacos de molécula pequeña fácilmente sintetizables, según una publicación en la revista Molecular Systems Biology.
El avance podría multiplicar las opciones para enfrentar las superbacterias como Staphylococcus aureus resistente a la meticilina (conocida por su sigla en inglés como MRSA), un problema grave en hospitales y cada vez más frecuente en la comunidad.
La investigación demostró que SyntheMol-RL puede dar con moléculas totalmente nuevas, capaces de frenar infecciones que hoy resultan difíciles de tratar “Estos resultados validan la capacidad de SyntheMol-RL para generar candidatos a antibióticos sintéticamente accesibles”, escribieron los científicos.
Uno de los compuestos generados, llamado synthecin, logró detener el avance de MRSA en un modelo con ratones. Los investigadores responsables del trabajo fueron Kyle Swanson, Gary Liu, Denise Catacutan, Stewart McLellan, Autumn Arnold, Megan Tu, Eric Brown, James Zou y Jonathan Stokes.
T/Agencias

